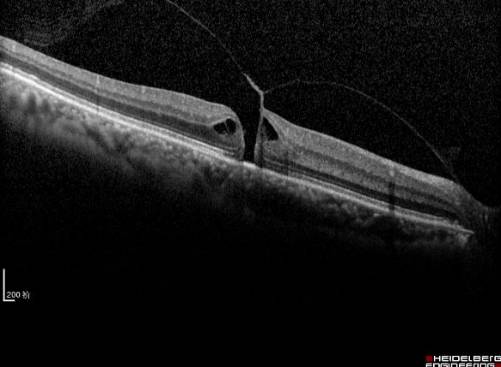
黄斑病变的克星,得了黄斑病变需要忌什么食物
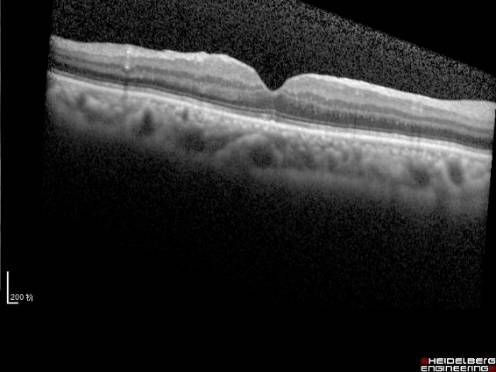
黄斑病变的克星,得了黄斑病变需要忌什么食物

导语
在以往的科普文章里我们已经告诉大家“黄斑”是眼睛里的一个正常结构,我们每个人都有。黄斑就像一部照相机的底片,它是眼底视网膜上最重要的结构,在2mm*2mm这个小小的区域里密集分布着几百万个感光细胞,赋予了我们敏锐的中心视力和色觉。但在过去很长的时间里,由于黄斑的解剖位置隐蔽,受检查设备以及手术技巧的限制,黄斑区一直是眼科的治疗禁区,面对黄斑疾病眼科医生们都感到束手无策。这些年,随着科技和医学的进步,陆续出现的检查手段和不断改良的手术技术,严重影响视力和色觉的黄斑疾病不再是不可治疗的,黄斑疾病患者与白内障患者一样,有了重见精彩世界的机会。
1、常见的黄斑疾病有哪些?
黄斑疾病多由先天发育异常或后天病损引起,临床上后者占绝大多数。一般来说,黄斑疾病多见于老年人,但目前黄斑疾病有低龄化和高发病的趋势。由于检查技术的日益精准,以往无法解释的视力问题越来越多的发现是由于黄斑部的细微病变造成的。常见的黄斑疾病包括年龄相关性黄斑变性(见图1)、特发性息肉状脉络膜血管病变、玻璃体黄斑牵拉综合征、黄斑前膜(见图2)、黄斑裂孔、高度近视黄斑病变(见图3)和中心性浆液性脉络膜视网膜病变等。

图1. 年龄相关性黄斑变性

图2. 黄斑前膜

图3. 高度近视眼底病变
2、黄斑疾病有什么症状?
(1)中心视力减退
黄斑部超精细的正常结构是敏锐视觉的基础。这个部位任何一点的细微变化都会引起视力的严重减退。绝大多数的黄斑疾病患者首诊的原因就是自觉视力急性或慢性的下降。
(2)视物变形,视物变小或变大
有一部分患者是因为看东西变形,在家里发现门框或窗框变得歪歪扭扭,或者因为两只眼看东西大小不一样来就诊,这是因为黄斑部感光细胞分布的密度、规律都有一定的模式,一旦发生出血或者水肿,都会影响病变区域内细胞的分布密度和走形格局,视觉上的表现就是视物变形,视物变小或变大(见图4)。
(3)视野中央黑影遮挡
黄斑部有新鲜出血时,患者多会抱怨眼前正中央有黑影遮挡,并且不随眼睛的转动而转动(见图4)。
(4)视物发暗
还有一些细心敏感的患者会发现一只眼睛看东西时比另一侧要发暗,有时候这是一些年轻中浆患者的第一就诊主诉。

图4
简单自测法
当出现以上症状时,就非常可能发生了“黄斑病变”。有一个非常简单易行的自测法可以初步自测:在家时可以挡住一只眼,先看视野中央是否有暗点遮挡。然后找一个门框或者窗框等垂直或者水平的一个物体,观察直线是否弯曲?两侧形状和颜色是否一致?眼科有一种特殊的检查表——Amsler表,当你看检查表上的方格,直线变扭曲,应该就是黄斑出现问题了,这个时候有必要到有眼底疾病检测能力的医院做进一步的检查确诊(见图5)。

图5. Amsler表检查 正常

各种异常表现
3、黄斑疾病治疗的“三大利器”
由于黄斑部特殊的解剖位置和极其复杂重要的视觉功能,黄斑病变的治疗都非常棘手。传统的药物治疗和激光治疗收效甚微。近年来出现的微创玻璃体手术、抗VEGF药物球内注射和光动力疗法(PDT)均是针对黄斑病变的治疗新手段,在实际临床应用中已经取得了意料之中的满意效果,给患者带来了不同程度的视力改善。
利器一:微创玻璃体手术
传统的玻璃体手术已有40多年的历史,操作复杂、手术创伤大、手术效果不确定。就像白内障手术的发展一样,眼科医生们不断改进手术方法,追求更安全有效、更微创的样式。现代玻璃体手术多采用25G或27G微创切口(见图6和图7),通过三个直径0.5mm-0.72mm的小针孔,技术精湛的医生在30分钟左右即可完成黄斑手术。术后三个小切口无需缝合,术眼舒适度高,几乎看不出手术遗留的疤痕。

图6. 玻璃体手术示意图

图7. 25G玻璃体手术术中
黄斑裂孔
随着年龄的增加,玻璃体浓缩、凝聚,玻璃体后界面与视网膜表面发生不同程度的后脱离。在脱离的过程中,由于在黄斑区域两者结合十分紧密,局部玻璃体黄斑牵拉,导致粘连的视网膜组织被撕脱下来,就形成了黄斑裂孔。因年龄造成的黄斑裂孔常无明确可循的原因,称为特发性黄斑裂孔。其他常见的原因还有外伤或高度近视等。黄斑裂孔一旦形成,会严重影响视力,应及时采取玻璃体手术封闭裂孔,可以有效阻止视力的进一步下降,术后视力提高的病例临床也不少见(见图8和图9)。
图8. 黄斑裂孔术前
图9. 黄斑裂孔术后(术者李勇)
玻璃体手术采用局部麻醉、术中无痛感。具体手术方法主要行玻璃体切除术后,切除黄斑区粘连的玻璃体,解除玻璃体黄斑牵拉,同时撕除裂孔周围的视网膜内界膜,封闭裂孔。术中有可能在玻璃体腔内填充气体,通过气泡的顶压作用促进裂孔愈合。极少数特殊患者,需要填充硅油。如果患者合并白内障,联合超声乳化白内障手术,植入合适的人工晶体,术后视力更令人满意(见图8和图9)。
目前黄斑手术进入了微创时代,手术创伤更小、效果更确定、患者几乎无痛苦。通过手术治疗,裂孔封闭率达到90%以上。当然,手术成功率与术后视力恢复情况主要取决于病程长短、裂孔大小、牵拉的程度范围,尤其是术者的手术技巧。黄斑手术联合白内障手术,术后有的患者视力可达到0.8以上。
黄斑前膜
黄斑区的结构细微精细,其表面还有玻璃体后皮质和视网膜内界膜,有的时候,在后皮质和内界膜之间,会增殖产生一种特殊的病理性膜结构,叫黄斑前膜(见图10)。这层膜结构,与内界膜紧相连,同时也和玻璃体的后皮质紧密相连,当膜的增生,加上玻璃体的牵拉,使得黄斑被牵拉起来,于是产生视物的变形、视力下降。一旦产生了上述症状就需要及时通过玻璃体手术剥除增殖膜阻止视力的恶化,手术时间短,并发症少,大多数患者视力保持稳定,部分患者视力逐步提高。

图10. 黄斑前膜
利器二、抗VEGF药物球内注射
目前,抗VEGF的主要治疗适应症有:湿性黄斑变性、息肉样脉络膜血管病变、高度近视黄斑脉络膜新生血管病变、视网膜静脉阻塞并发黄斑水肿、糖尿病视网膜病变合并黄斑水肿、新生血管性青光眼、早产儿视网膜病变、玻璃体视网膜手术前辅助用药。
抗VEGF药物属于注射用药物,给药方式是眼球内注射(玻璃体腔内注射),简单易行,患者无痛苦(见图11),并且根据病情的需要,可以重复注射。术前术后常规点抗生素眼药水数天,定期门诊随访复诊即可。有研究表明在原来势必要失明的患者中,有1/3的患者视力可以提高,有1/3的患者视力稳定,而有1/3的患者无效。

图11. 玻璃体腔内注射抗VEGF药物示意图
利器三:光动力疗法(photodynamic therapy, PDT)
光动力疗法是在光敏剂的引导下,通过一种特殊的非热能激光照射,破坏黄斑部异常的新生血管,从而减少黄斑区病变组织的出血、水肿和渗出,稳定患者视力,提高患者生活质量,是一种目前国内外公认的治疗黄斑脉络膜新生血管(CNV)的安全有效微创的新技术。PDT主要用于治疗湿性黄斑变性、病理性近视合并黄斑病变、中心性渗出性视网膜病变、中心性浆液性视网膜脉络膜病变等黄斑部新生血管疾病。对于某些对抗VEGF药物治疗反应迟缓或者耐受的CNV患者,可联合或者更改为PDT治疗,往往会取得一些令人满意的治疗效果(见图12)。

图12. 息肉样脉络膜血管病变抗VEGF联合PDT治疗前后眼底和OCT对比图
综上,一旦您或者您的亲戚朋友出现本文开头所述的视力下降或视物变形等症状,切不可误以为是白内障,拖延不就诊。黄斑疾病拖延的越久,对视网膜细胞的不可逆损伤越大,术后功能的恢复越有限。所以,请务必及时到眼科诊治,明确病因,早发现,早治疗。微创玻璃体手术、抗VEGF药物和PDT这三大治疗利器会为黄斑疾病患者的视力预后提供安全有效的保障。
作者简介:


文、图片 by 李勇
编辑 by 外联宣传部
(来源:上海市眼病防治中心)